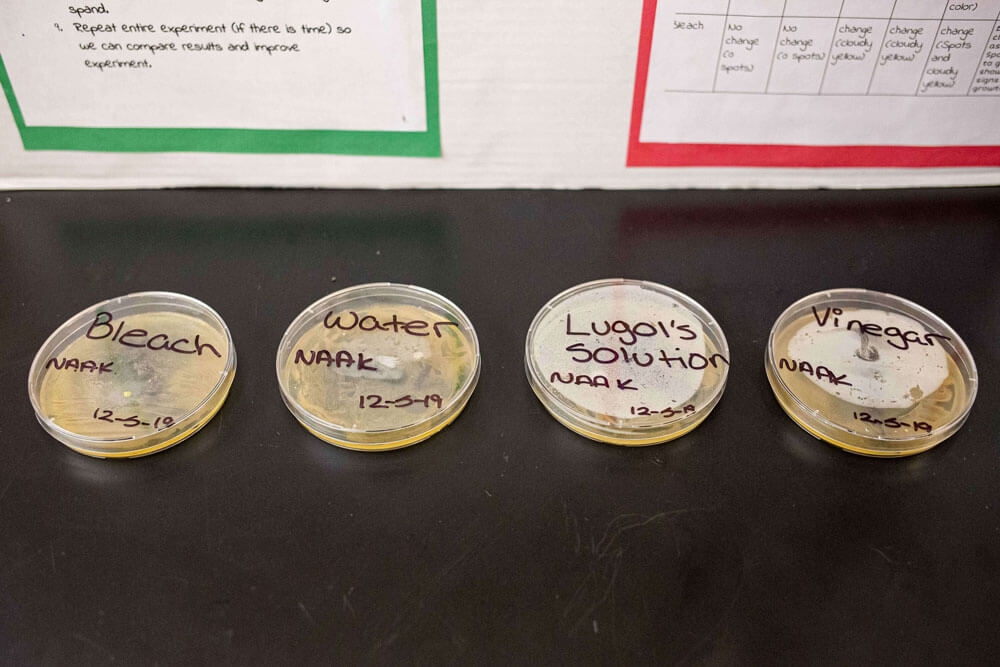
moldsamples

When it comes to science, SA scholars aren’t afraid to get messy — but sixth grader Kiahsolae Bernard can tell you how to clean up your act! For this year’s Science Symposium, Kiah and her SA Queens 1 Middle School teammates Nia Roberts, Abiola Ilesanmi and Amiyah Peacock set out to discover the best product for keeping your home clean. In a city like New York, their investigation couldn’t be more relevant, and the team was eager to share their results with friends and family.
The annual Science Symposium is a month-long middle school science unit dedicated to scholar-led research projects, culminating in a showcase of findings and lessons learned. We were excited to catch up with Kiah and her teacher Genique Green to hear more about their project — and to find out which product we should all be using to keep bad bacteria at bay! Read about Kiah’s cleaning clues, the role teamwork plays in successful scientific discovery, and how Ms. Green encourages her scholars to learn from setbacks:
What was the motivation behind conducting this experiment?
Kiah: Everyone knows that germs and bad bacteria can make us sick. Our goal was to help people keep their homes clean by finding the best solution. We designed an experiment to test four popular cleaning products: vinegar, water, bleach, and the disinfectant Lugol’s solution. We poured a small amount into petri dishes and looked at how the substances changed over six days. Our hypothesis was that bleach would be the best cleaner — bleach seems very strong! — but the result was a surprise. The best part about choosing this problem as our science experiment was sharing our findings with our parents, who told us that they really learned from us. Most of them use bleach for cleaning, so they were just as surprised as we were to find out that there might be a better product: Lugol’s solution!
Ms. Green: Great science projects involve testable questions with a real world purpose — something that can change not just the scientific community, but the way people go about their lives. This is fundamental to our approach to teaching science, and it especially comes to fruition during Symposium. I want my scholars to hone a problem-solving mindset, not just for the sake of completing an experiment, but to think big about the ways they can change the world.

How did the group overcome challenges?
Kiah: During the experiment, we were a little sad that the bacterial growth didn’t look the way we thought it would. Other students in our class saw bacteria cultures form in green, yellow, or reddish circles, but ours appeared in the vinegar, bleach, and water dishes as yellow and cloudy instead. After a lot of talking together, we decided as a team that we would make a conclusion from our observations that we all felt good about. Since the Lugol’s dish was still clear by the end, we agreed that it seemed the best option for cleaning and fighting bacteria.
Ms. Green: In preparing for the Symposium, scholars learned to work with their team toward a common goal. There were times when they disagreed about the best approach or decision, but they knew they had to work together to solve the same problem. For example, when they were in the early stages of designing the project, they had differing opinions on which solutions they wanted to test. They considered limiting their experiment to clothing detergents, but ultimately determined that they wanted to test solutions that could be used to clean anything at all, and that had more of an impact on everyday life. They wanted to make their project as broadly applicable to day-to-day life as possible.
As they worked out the details of project design, I saw them listen to each other, defend their ideas, and consider new points of view. One of the challenges as a teacher throughout this process is knowing when to stand back and let the scholars work through setbacks on their own, and when to step in with some encouragement or guidance.
How does it feel to design and conduct an experiment from start to finish?
Kiah: It was fun to be in charge of our experiment. We couldn’t just ask Ms. Green for the answer — we had to do research and try something new, like when we had to change our procedure after we started our experiment. At first we had our petri dishes in the light, but we weren’t seeing any changes. We went back to researching and learned that bacteria grows best in dark places. We moved the dishes into the dark, and were finally able to finally see some changes!
Ms. Green: Generating their own data gave scholars a sense of ownership over their projects, and seeing an experiment through from start to finish taught them how to use a set of data to draw a conclusion. In the case of Kiah’s group, the data didn’t prove their hypothesis — they saw evidence of bacteria in their bleach, but not in Lugol’s solution — and they had to trust that their data was leading them to an accurate conclusion.
Failure and flexibility are so important for science — it’s proven that we can actually learn more from failure than when everything goes according to plan. A key part of science at Success is teaching scholars to adopt a problem-solving lens and embrace the ups and downs of the discovery process.
Cover photo: Amiyah Peacock, Genique Green, and Kiahsolae Bernard










